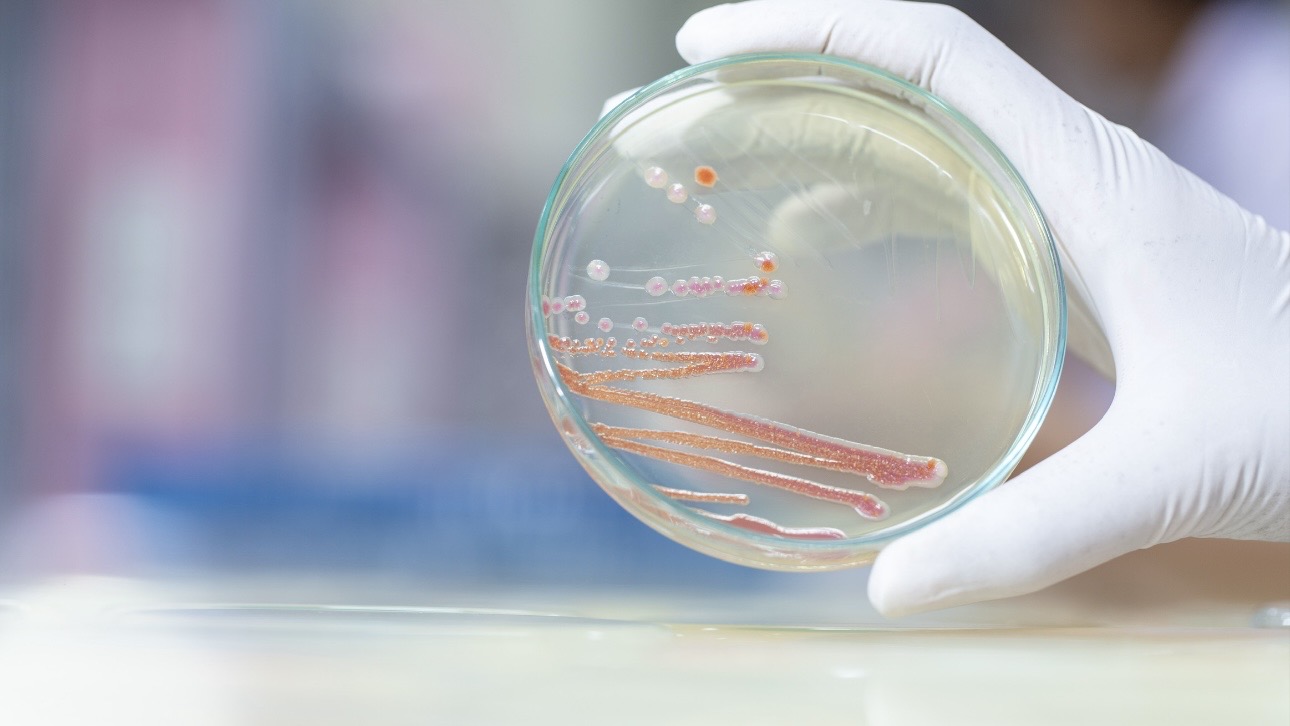
Почему умерли девять младенцев в роддоме Новокузнецка

«Настоящий монстр»: какая бактерия убила девять младенцев в роддоме Новокузнецка
Сюжет:
Эксклюзивы ВМБактериальная вспышка серрации марцесценс стала причиной гибели младенцев в роддоме № 1 в Новокузнецке. Об этом заявил эпидемиолог, академик РАН Геннадий Онищенко. «Вечерняя Москва» узнала у врача-инфекциониста, дерматолога, аккредитованного хирурга, доктора медицинских наук Марият Мухиной, как бактерия могла попасть в медицинское учреждение и можно ли было это предотвратить.
По ее словам, серрация марцесценс — это условно-патогенная грамотрицательная бактерия, которая часто вызывает опасные внутрибольничные инфекции, особенно у пациентов со сниженным иммунитетом.
— Серрация марцесценс — очень злостная внутрибольничная инфекция, которая вызывает менингит, сепсис, абсцессы головного мозга, остеомиелит, пиелонефрит, пневмонию и многие другие опасные заболевания. При назначении лечения пациент должен пройти обследование на индивидуальную чувствительность к антибиотикам, — сказала она.
Врач отметила, что эта бактерия попадает в больницы и роддома через внешнюю среду, воду, почву. Она, как контактная инфекция, может передаваться через руки персонала или медицинские инструменты.
— Раньше, когда медицина не была настолько развита, как в наши дни, роддома и больницы даже сжигали и сносили, не строили на этом месте другие здания, потому что бактерия серрация марцесценс очень патогенная. Она проникает в воздух, стены, кирпичную кладку, образуя пигментные пятна красноватого цвета. Ее невозможно вытравить никакими способами, — говорит Мухина.
Специалист объяснила, что внутрибольничный штамм серрация марцесценс особенно опасен тем, что адаптирован ко многим видам антибиотиков.
— Это настоящий бактериальный монстр, который умеет противостоять антибиотикам. Если бактерия попадает в здание, то начинает создавать колонии, которые также становятся устойчивыми к средствам антисептической обработки, — сообщила собеседница «ВМ».
Инфекционист подчеркнула, что в медицинских учреждениях обязательно должны проводить регулярную антисептическую обработку, меняя средства дезинфекции, чтобы бактерия серрация марцесценс не успела к ним привыкнуть и не смогла прижиться в здании.
— Санитарная уборка должна проводиться антисептиками, а раз в полгода их нужно менять, чтобы она к ним не адаптировалась. Только такой способ позволит не допустить ее размножения в стенах больничных учреждений и не подвергать риску пациентов, — заключила она.
Ранее стало известно, что работу роддома № 1 в Новокузнецке, где ранее за короткий срок скончались девять младенцев, приостановили на 90 суток. Уточняется, что представитель администрации роддома признал вину юридического лица. Суд арестовал главного врача учреждения, а главу регионального Минздрава Андрея Тарасова раскритиковали за равнодушие к трагедии.